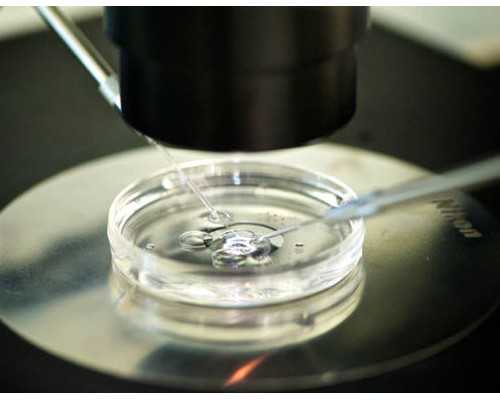
深圳助孕成功后付款,深圳北大试管成功率大吗?一次能成功吗?

一、深圳有没有女的助孕
1、当你决定选择做试管婴儿手术时,你会发现每个试管婴儿的成功率可能没有我们想象的那么理想。深圳北大试管成功率对很多人起着至关重要的作用。在选择做试管婴儿成功率的过程中,一定要综合各种情况进行有效分析。众所周知,如果我们选择在深圳的任何地方做试管婴儿手术,他们的成功率可能会有所不同。毕竟每个病人的情况都会不一样。
2、北大医院试管成功率大吗?
3、当你决定选择在深圳这家医院做试管婴儿手术时,成功率几乎在30%~60%之间,但随着女性年龄的逐渐增长,这种概率呈下降趋势。一般来说,30岁以下的女性在深圳选择试管婴儿的成功率可能会达到60%以上,30-35岁之间的成功率可能会达到50%以上。年龄在35-40岁之间,成功率在40%以下,40-45岁之间,成功率在20%左右。
4、如何提高试管婴儿的成功率?
5、在我们选择做试管婴儿手术之前,我们必须通过采集血样来提高试管婴儿的成功率。这样,我们可以检查激素水平,看看他们是否有染色体感染问题。如果是男性,他们需要做一些精液检查,这样他们就可以检查精子的数量或运动力。因此,如果他们打算做试管婴儿手术,夫妻双方都应该提前半年进行身体调理,这也有利于提高试管婴儿的成功率。
6、当你选择做试管婴儿手术时,你必须特别注意试管婴儿的手术。你应该清楚地了解整个过程。不要给自己施加压力,让我们的身体达到最佳状态。只有这样,我们才能在选择手术的过程中,全面了解所有试管婴儿手术的标准流程,无论在哪个环节,我们都必须特别注意每个环节的具体情况,通过促进排卵检查卵泡生长,取出卵子,体验试管婴儿手术。
7、深圳特产有哪些?深圳本土有什么特色礼品?深圳,这座大都市,汇聚国内外各地特产美食,很多人都觉得深圳没有什么特产,来深圳旅游或者回家探亲也不知道买什么。其实,深圳还是有自己本地的特产的,以下小编就为您整理些深圳本土的特产礼品。
8、沙井蚝,也就是牡蛎。沙井地处珠江出海口,咸淡水交汇,终年气候温和,海水咸度适中,浮游生物繁多,是得天独厚的养蚝区。产于沙井的蚝,个体肥壮,色泽乳白,肉质嫩美,富含蛋白质和维生素,含碘量是牛奶和蛋黄的200倍,肥嫩爽滑著称省港澳和东南亚。
9、02【深圳香辣鱼仔酱】
10、南派香辣味,采用传统古方秘制、优选南海白公鱼干,兼备活鱼的鲜、干鱼的爽、咸鱼的味,配以上乘红椒、独特配料及工艺,营养健康、风味独特。
二、深圳试管助孕费用
1、安琪食品荣誉出品,马来西亚风味,多种口感组合,粒粒饱满、色泽金黄、坚果的芳香与酥饼中的奶香味完美融合,香浓酥脆不油腻、回味无穷。
2、广式腊肠是中国的传统食品,历史悠久。曾荣膺“最能代表25年深圳形象”的深圳名片“喜上喜”腊肠采用冷鲜肉为主要原料经现代生产工艺加工而成。咸淡适中、鲜美可口、腊香明显、红白分明、酒香浓郁,是最正宗最地道的广式风味。
3、05【盘中香特级初榨橄榄油】
4、来自西班牙原液进口灌装的盘中香特级初榨橄榄油在西方被誉为“液体黄金”、“植物油皇后”、“地中海甘露”,其极佳的天然保健功效、美容功能和理想的烹调用途,已成为健康、营养、时尚人群的最爱。
5、06【蜜雪儿冰葡萄酒】
6、蜜雪儿冰酒采用100%加拿大进口浓缩冰葡萄原汁灌装,原料产自全世界最寒冷的葡萄栽培区省,此地“夏季极热,冬季极冷”,昼夜温差悬殊,且日照充足,降雨量少,土质肥沃,无任何污染。得天独厚的气候环境和自然地貌,为冰酿葡萄种植生长提供了近乎完美的生物条件,温差殊异冷热交替,使冰酿葡萄在完全自然状态中不断冰冻。
7、07【鹰牌花旗参含片】
8、鹰牌为保健品行业知名品牌,深圳制造。鹰牌野山花旗参含片以野山花旗参、山梨醇为主要原料制成的,经功能试验证实,具有免疫调节的保健作用,可增强人体免疫力,提高机体抵抗力。
9、08-1【永福元桂圆肉】(季节性选装)
10、深圳市永福元工贸有限公司出品。精选岭南桂圆加工而成,颗颗饱满、粒粒精华、肉质厚嫩、口味鲜甜、不增加任何添加剂,具有良好的滋养补益作用。